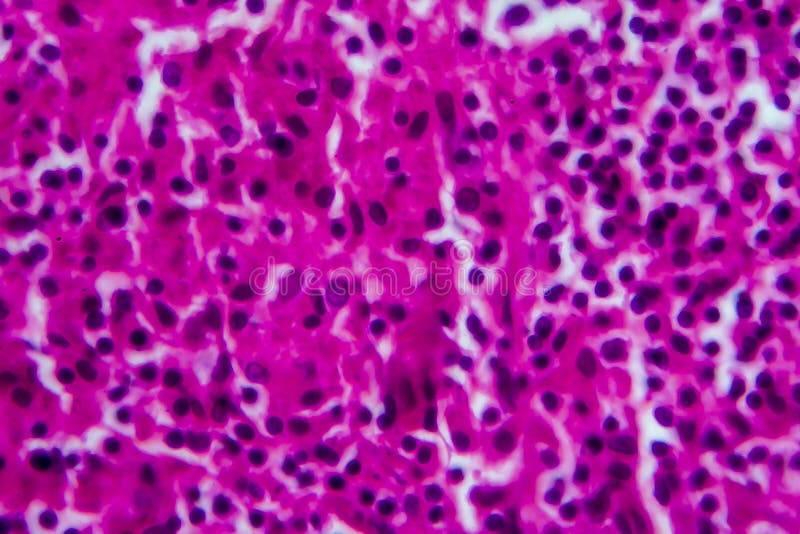

Cell rise
Обустроить 4 сотки
Минусы полипропиленовых труб
555 евро
Все процессоры v3
Расселение германцев история 6
Pixma 1600
Все песни загира магомедова слушать
Периодический закон системы элементов менделеева кратко
Маховик стартерный
Аудиосказка для детей 13
62 сш 34 вд какой город
Станция макс описание
Continental conti ice 3
Cell rise 107 фото